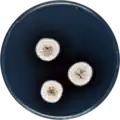
Aspergillus austroafricanus growing on CYA plate

Aspergillus austroafricanus
| Aspergillus austroafricanus | |
|---|---|
| Scientific classification | |
| Kingdom: | Fungi |
| Division: | Ascomycota |
| Class: | Eurotiomycetes |
| Order: | Eurotiales |
| Family: | Aspergillaceae |
| Genus: | Aspergillus |
| Species: | A. austroafricanus
|
| Binomial name | |
| Aspergillus austroafricanus Jurjević, S.W. Peterson & B.W. Horn (2012)[1]
| |
Aspergillus austroafricanus is a species of fungus in the genus Aspergillus. It is from the Versicolores section.[1] The species was first described in 2012.[1] It has been isolated in South Africa.[1]
Growth and morphology
A. austroafricanus has been cultivated on both Czapek yeast extract agar (CYA) plates and Malt Extract Agar Oxoid® (MEAOX) plates. The growth morphology of the colonies can be seen in the pictures below.
-
Aspergillus austroafricanus growing on CYA plate
Aspergillus austroafricanus growing on CYA plate -
 Aspergillus austroafricanus growing on MEAOX plate
Aspergillus austroafricanus growing on MEAOX plate
References
Further reading
- Ebrahim W, El-Neketi M, Lewald LI, Orfali RS, Lin W, Rehberg N, Kalscheuer R, Daletos G, Proksch P (2016). "Metabolites from the Fungal Endophyte Aspergillus austroafricanus in Axenic Culture and in Fungal–Bacterial Mixed Cultures". Journal of Natural Products. 79 (4): 914–922. doi:10.1021/acs.jnatprod.5b00975. PMID 27070198.
- Tsang CC, Hui TW, Lee KC, Chen JH, Ngan AH, Tam EW, Chan JF, Wu AL, Cheung M, Tse BP, Wu AK, Lai CK, Tsang DN, Que TL, Lam CW, Yuen KY, Lau SK, Woo PC (2016). "Genetic diversity of Aspergillus species isolated from onychomycosis and Aspergillus hongkongensis sp. nov., with implications to antifungal susceptibility testing". Diagn. Microbiol. Infect. Dis. 84 (2): 125–34. doi:10.1016/j.diagmicrobio.2015.10.027. PMID 26658315.